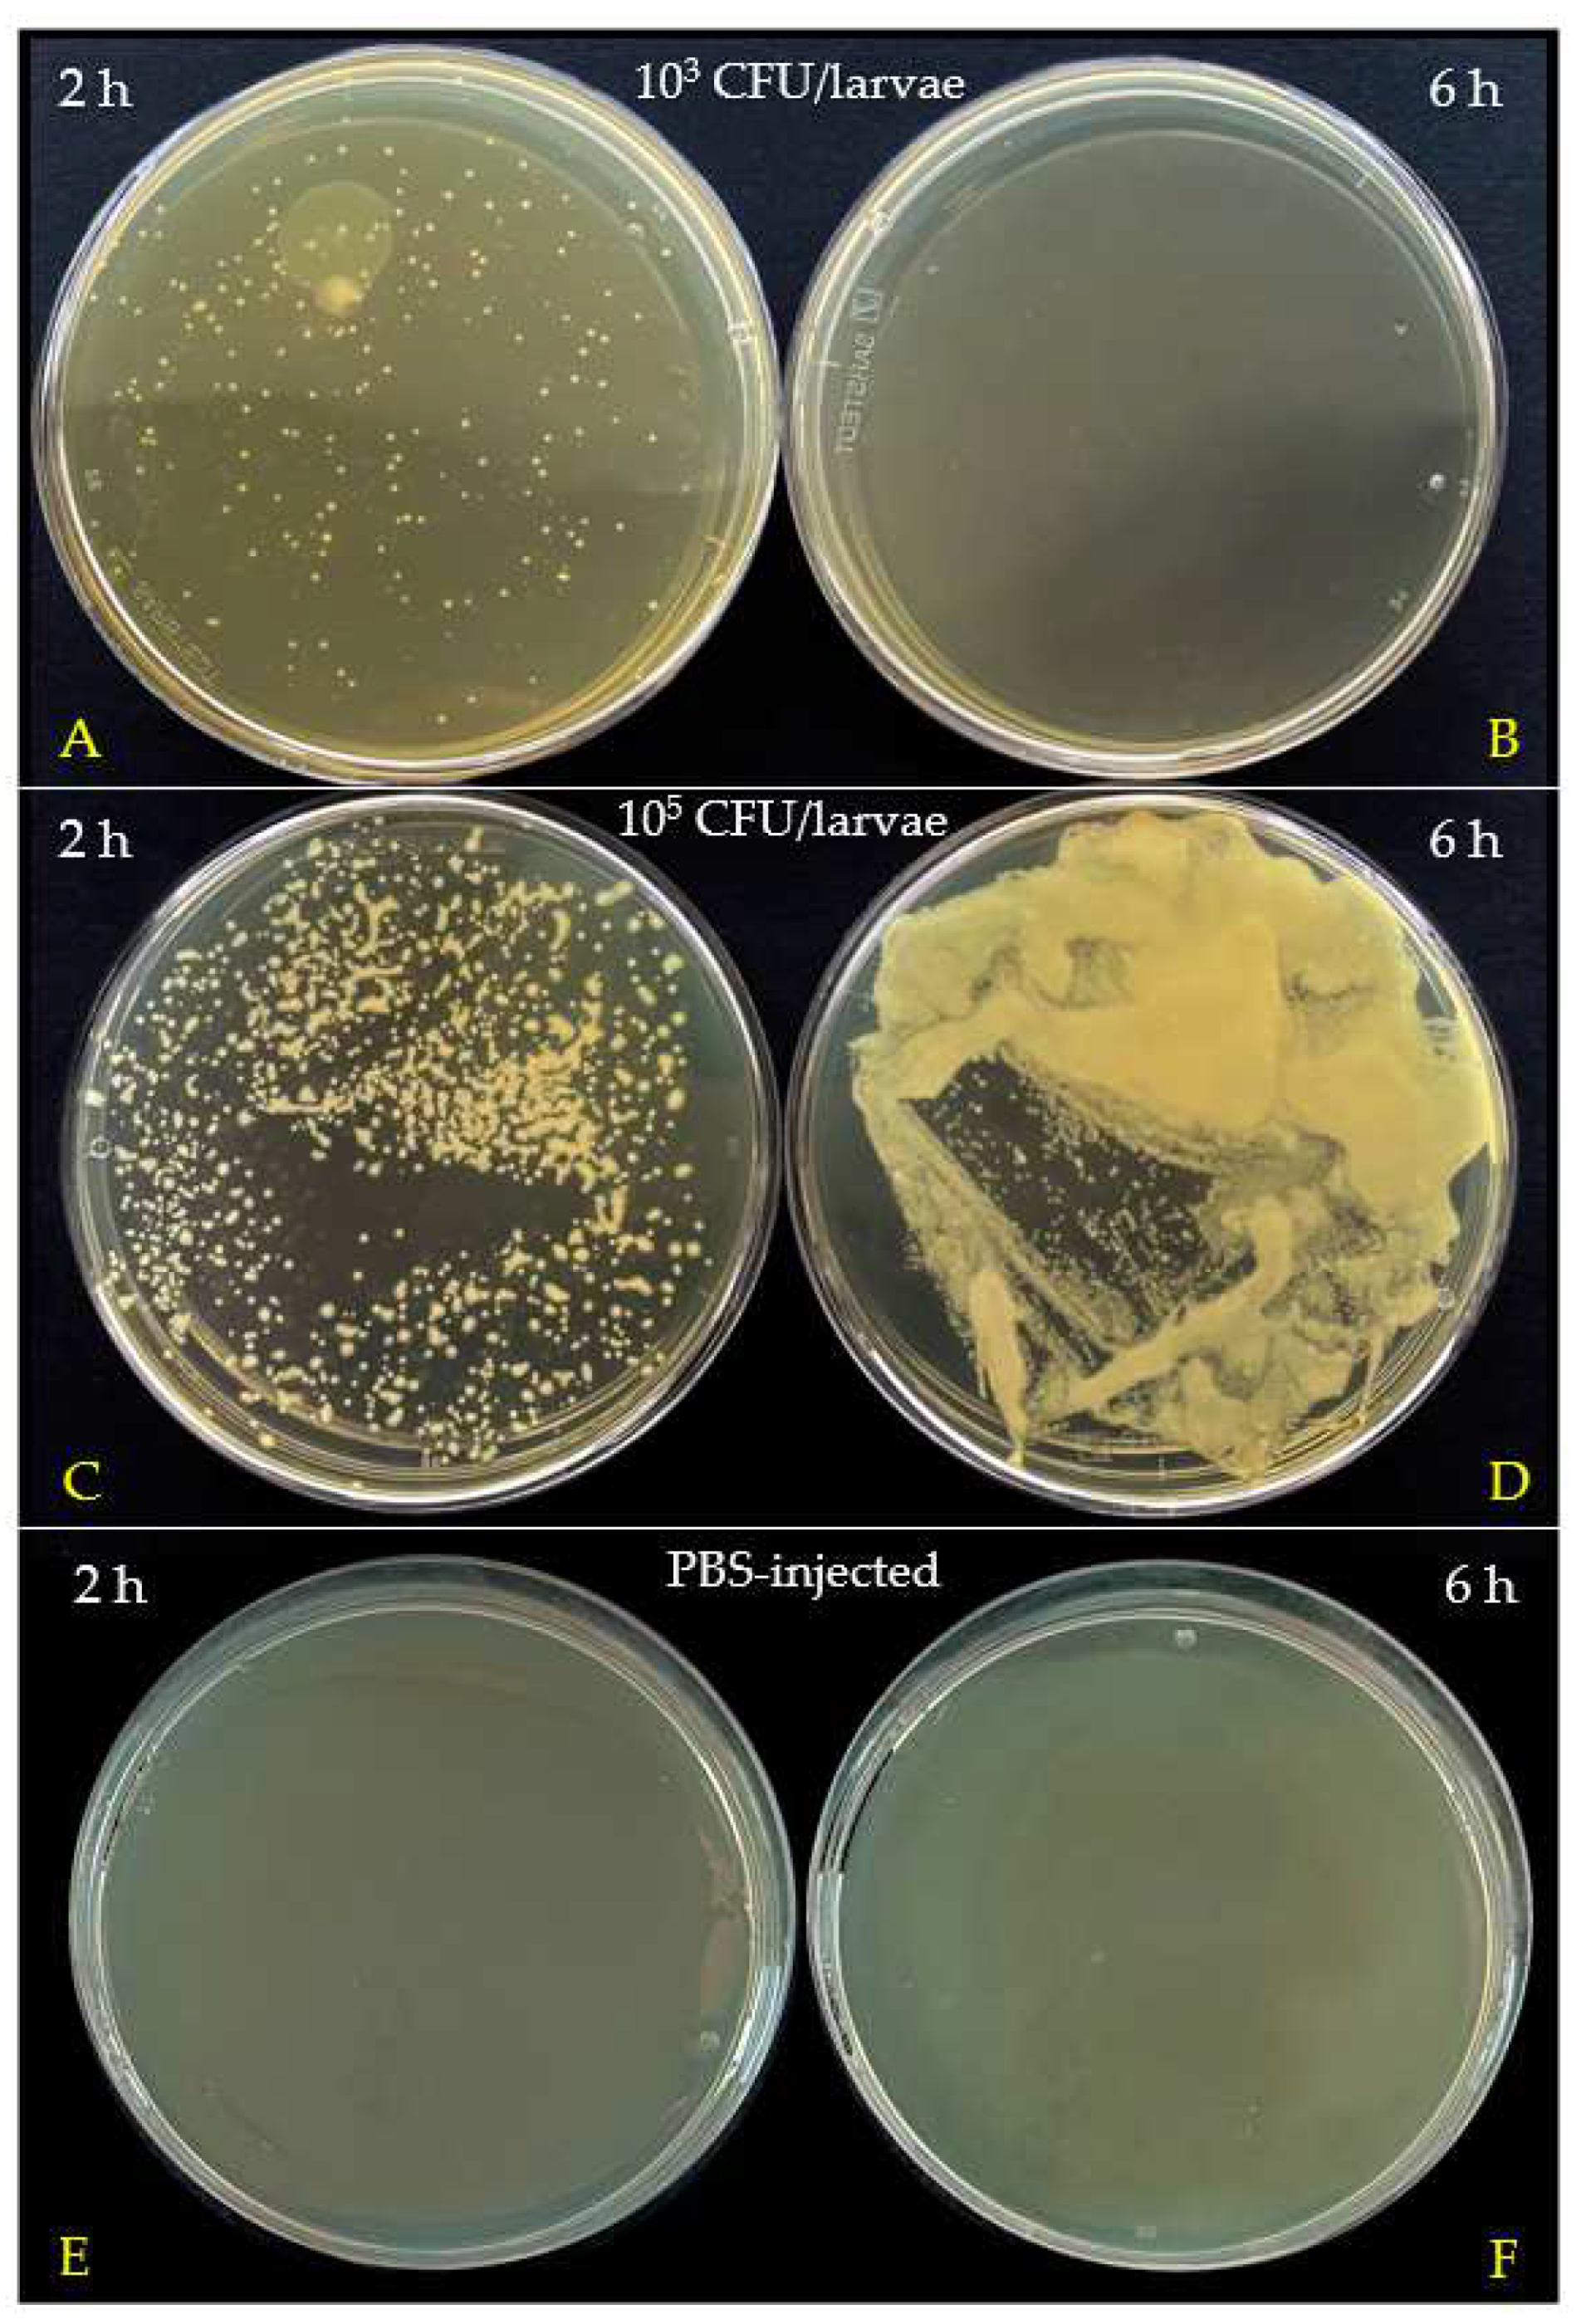

Optimization of Experimental Infection of the Animal Model Galleria mellonella Linnaeus 1758 (Lepidoptera: Pyralidae) with the Gram-Positive Bacterium Micrococcus luteus
Abstract
Simple Summary
Abstract
1. Introduction
2. Materials and Methods
2.1. Chemicals and Instruments
2.2. G. mellonella Rearing and Maintaining Conditions
2.3. Cultures of M. luteus
2.4. M. luteus Growth Curve and Colony Counts
2.5. Infection of G. mellonella Larvae and Bacterial Clearance
2.6. Statistical Analysis
3. Results
3.1. Growth Assessment of M. luteus
3.2. Survival of G. mellonella after Infection with M. luteus
3.3. Bacterial Clearance in G. mellonella Hemolymph
4. Discussion
5. Conclusions
Author Contributions
Funding
Data Availability Statement
Acknowledgments
Conflicts of Interest
References
- Maestri, E. The 3rs Principle in Animal Experimentation: A Legal Review of the State of the Art in Europe and the Case in Italy. BioTech 2021, 10, 9. [Google Scholar] [CrossRef] [PubMed]
- Hubrecht, R.C.; Carter, E. The 3Rs and Humane Experimental Technique: Implementing Change. Animals 2019, 9, 754. [Google Scholar] [CrossRef]
- Hickman, D.L.; Johnson, J.; Vemulapalli, T.H.; Crisler, J.R.; Shepherd, R. Commonly Used Animal Models. In Principles of Animal Research for Graduate and Undergraduate Students; Elsevier Inc.: Amsterdam, The Netherlands, 2017; pp. 117–175. ISBN 9780128023662. [Google Scholar]
- Carlsson, H.E.; Schapiro, S.J.; Farah, I.; Hau, J. Use of Primates in Research: A Global Overview. Am. J. Primatol. 2004, 63, 225–237. [Google Scholar] [CrossRef] [PubMed]
- Lee, H.Y.; Lee, S.H.; Min, K.J. Insects as a Model System for Aging Studies. Entomol. Res. 2015, 45, 1–8. [Google Scholar] [CrossRef]
- Scharrer, B. Insects as Models in Neuroendocrine Research. Annu. Rev. Entomol. 1987, 32, 1–16. [Google Scholar] [CrossRef]
- Simons, M.; Tibbetts, E. Insects as Models for Studying the Evolution of Animal Cognition. Curr. Opin. Insect Sci. 2019, 34, 117–122. [Google Scholar] [CrossRef] [PubMed]
- Matsumoto, Y. Facilitating Drug Discovery in Human Disease Models Using Insects. Biol. Pharm. Bull. 2020, 43, 216–220. [Google Scholar] [CrossRef]
- Kwadha, C.A.; Ong’Amo, G.O.; Ndegwa, P.N.; Raina, S.K.; Fombong, A.T. The Biology and Control of the Greater Wax Moth, Galleria mellonella. Insects 2017, 8, 61. [Google Scholar] [CrossRef]
- Junqueira, J.C. Galleria mellonella as a Model Host for Human Pathogens: Recent Studies and New Perspectives. Virulence 2012, 3, 474–476. [Google Scholar] [CrossRef]
- Piatek, M.; Sheehan, G.; Kavanagh, K. Galleria mellonella: The Versatile Host for Drug Discovery, In Vivo Toxicity Testing and Characterising Host-Pathogen Interactions. Antibiotics 2021, 10, 1545. [Google Scholar] [CrossRef]
- Cutuli, M.A.; Petronio Petronio, G.; Vergalito, F.; Magnifico, I.; Pietrangelo, L.; Venditti, N.; Di Marco, R. Galleria mellonella as a Consolidated In Vivo Model Hosts: New Developments in Antibacterial Strategies and Novel Drug Testing. Virulence 2019, 10, 527–541. [Google Scholar] [CrossRef] [PubMed]
- Ménard, G.; Rouillon, A.; Cattoir, V.; Donnio, P.Y. Galleria mellonella as a Suitable Model of Bacterial Infection: Past, Present and Future. Front. Cell. Infect. Microbiol. 2021, 11, 782733. [Google Scholar] [CrossRef] [PubMed]
- Brivio, M.F.; Mastore, M. Nematobacterial Complexes and Insect Hosts: Different Weapons for the Same War. Insects 2018, 9, 117. [Google Scholar] [CrossRef] [PubMed]
- Tsai, C.J.Y.; Loh, J.M.S.; Proft, T. Galleria mellonella Infection Models for the Study of Bacterial Diseases and for Antimicrobial Drug Testing. Virulence 2016, 7, 214–229. [Google Scholar] [CrossRef] [PubMed]
- Loulou, A.; Mastore, M.; Caramella, S.; Bhat, A.H.; Brivio, M.F.; Machado, R.A.R.; Kallel, S. Entomopathogenic Potential of Bacteria Associated with Soil-Borne Nematodes and Insect Immune Responses to Their Infection. PLoS ONE 2023, 18, e0280675. [Google Scholar] [CrossRef] [PubMed]
- Shi, X.; Qiu, S.; Ji, L.; Lu, H.; Wu, S.; Chen, Q.; Zou, X.; Hu, Q.; Feng, T.; Chen, S.; et al. Pathogenetic Characterization of a Micrococcus luteus Strain Isolated from an Infant. Front. Pediatr. 2023, 11, 1303040. [Google Scholar] [CrossRef]
- Zhu, M.; Zhu, Q.; Yang, Z.; Liang, Z. Clinical Characteristics of Patients with Micrococcus Luteus Bloodstream Infection in a Chinese Tertiary-Care Hospital. Pol. J. Microbiol. 2021, 70, 321–326. [Google Scholar] [CrossRef] [PubMed]
- de Jong, A.W.; van Veldhuizen, D.; Groot, A.T.; Hagen, F. Standardized Methods to Rear High-Quality Galleria mellonella Larvae for the Study of Fungal Pathogens. Entomol. Exp. Appl. 2022, 170, 1073–1080. [Google Scholar] [CrossRef]
- Coico, R. Gram Staining. Curr. Protoc. Microbiol. 2006, 3, A.3C.1–A.3C.2. [Google Scholar] [CrossRef]
- Mastore, M.; Brivio, M.F. Basic Methods to Evaluate Humoral Immunity Processes in Lepidoptera Larvae. In Immunity in Insects; Sandrelli, F., Tettamanti, G., Eds.; Springer: New York, NY, USA, 2020; pp. 127–144. ISBN 978-1-0716-0259-1. [Google Scholar]
- Pereira, T.C.; De Barros, P.P.; Fugisaki, L.R.d.O.; Rossoni, R.D.; Ribeiro, F.d.C.; De Menezes, R.T.; Junqueira, J.C.; Scorzoni, L. Recent Advances in the Use of Galleria mellonella Model to Study Immune Responses against Human Pathogens. J. Fungi 2018, 4, 128. [Google Scholar] [CrossRef]
- Pereira, M.F.; Rossi, C.C.; da Silva, G.C.; Nogueira Rosa, J.; Soares Bazzolli, D.M. Galleria mellonella as an infection model: An in-depth look at why it works and practical considerations for successful application. Pathog. Dis. 2020, 78, ftaa056. [Google Scholar] [CrossRef] [PubMed]
- Loh, J.M.S.; Adenwalla, N.; Wiles, S.; Proft, T. Galleria mellonella Larvae as an Infection Model for Group A Streptococcus. Virulence 2013, 4, 419–428. [Google Scholar] [CrossRef]
- Olsen, R.J.; Ebru Watkins, M.; Cantu, C.C.; Beres, S.B.; Musser, J.M. Virulence of Serotype M3 Group a Streptococcus Strains in Wax Worms (Galleria mellonella Larvae). Virulence 2011, 2, 111–119. [Google Scholar] [CrossRef]
- Evans, B.A.; Rozen, D.E. A Streptococcus Pneumoniae Infection Model in Larvae of the Wax Moth Galleria mellonella. Eur. J. Clin. Microbiol. Infect. Dis. 2012, 31, 2653–2660. [Google Scholar] [CrossRef]
- Hanin, A.; Sava, I.; Bao, Y.Y.; Huebner, J.; Hartke, A.; Auffray, Y.; Sauvageot, N. Screening of In Vivo Activated Genes in Enterococcus faecalis during Insect and Mouse Infections and Growth in Urine. PLoS ONE 2010, 5, e11879. [Google Scholar] [CrossRef] [PubMed]
- Gaspar, F.; Teixeira, N.; Rigottier-Gois, L.; Marujo, P.; Nielsen-LeRoux, C.; Crespo, M.T.B.; de Fátima Silva Lopes, M.; Serror, P. Virulence of Enterococcus faecalis Dairy Strains in an Insect Model: The Role of FsrB and GelE. Microbiology 2009, 155, 3564–3571. [Google Scholar] [CrossRef]
- Sheehan, G.; Garvey, A.; Croke, M.; Kavanagh, K. Innate Humoral Immune Defences in Mammals and Insects: The Same, with Differences? Virulence 2018, 9, 1625–1639. [Google Scholar] [CrossRef]
- Lebreton, F.; Le Bras, F.; Reffuveille, F.; Ladjouzi, R.; Giard, J.-C.; Leclercq, R.; Cattoir, V. Galleria mellonella as AModel for Studying Enterococcus faecium Host Persistence. J. Mol. Microbiol. Biotechnol. 2012, 21, 191–196. [Google Scholar] [CrossRef]
- Lebreton, F.; van Schaik, W.; Sanguinetti, M.; Posteraro, B.; Torelli, R.; Le Bras, F.; Verneuil, N.; Zhang, X.; Giard, J.C.; Dhalluin, A.; et al. AsrR Is an Oxidative Stress Sensing Regulator Modulating Enterococcus faecium Opportunistic Traits, Antimicrobial Resistance, and Pathogenicity. PLoS Pathog. 2012, 8, e1002834. [Google Scholar] [CrossRef]
- Quiblier, C.; Seidl, K.; Roschitzki, B.; Zinkernagel, A.S.; Berger-Bächi, B.; Senn, M.M. Secretome Analysis Defines the Major Role of SecDF in Staphylococcus aureus Virulence. PLoS ONE 2013, 8, e63513. [Google Scholar] [CrossRef] [PubMed]
- Peleg, A.Y.; Monga, D.; Pillai, S.; Mylonakis, E.; Moellering, R.C.; Eliopoulos, G.M. Reduced Susceptibility to Vancomycin Influences Pathogenicity in Staphylococcus aureus Infection. J. Infect. Dis. 2009, 199, 532–536. [Google Scholar] [CrossRef]
- Silva, L.N.; Da Hora, G.C.A.; Soares, T.A.; Bojer, M.S.; Ingmer, H.; Macedo, A.J.; Trentin, D.S. Myricetin Protects Galleria mellonella against Staphylococcus aureus Infection and Inhibits Multiple Virulence Factors. Sci. Rep. 2017, 7, 2823. [Google Scholar] [CrossRef] [PubMed]
- Joyce, S.A.; Gahan, C.G.M. Molecular Pathogenesis of Listeria Monocytogenes in the Alternative Model Host Galleria mellonella. Microbiology 2010, 156, 3456–3468. [Google Scholar] [CrossRef] [PubMed]
- Mukherjee, K.; Mraheil, M.A.; Silva, S.; Müller, D.; Cemic, F.; Hemberger, J.; Hain, T.; Vilcinskas, A.; Chakraborty, T. Anti-Listeria Activities of Galleria mellonella Hemolymph Proteins. Appl. Environ. Microbiol. 2011, 77, 4237–4240. [Google Scholar] [CrossRef] [PubMed]
- Kordaczuk, J.; Sułek, M.; Mak, P.; Śmiałek-Bartyzel, J.; Hułas-Stasiak, M.; Wojda, I. Defence Response of Galleria mellonella Larvae to Oral and Intrahemocelic Infection with Pseudomonas entomophila. Dev. Comp. Immunol. 2023, 147, 104749. [Google Scholar] [CrossRef]
- Fallon, J.P.; Troy, N.; Kavanagh, K. Pre-Exposure of Galleria mellonella Larvae to Different Doses of Aspergillus fumigatus Conidia Causes Differential Activation of Cellular and Humoral Immune Responses. Virulence 2011, 2, 413–421. [Google Scholar] [CrossRef]
- Brivio, M.F.; Moro, M.; Mastore, M. Down-Regulation of Antibacterial Peptide Synthesis in an Insect Model Induced by the Body-Surface of an Entomoparasite (Steinernema feltiae). Dev. Comp. Immunol. 2006, 30, 627–638. [Google Scholar] [CrossRef] [PubMed]
- Kavanagh, K.; Reeves, E.P. Insect and Mammalian Innate Immune Responses Are Much Alike. Microbe 2007, 2, 596–599. [Google Scholar] [CrossRef]
- Banville, N.; Browne, N.; Kavanagh, K. Effect of Nutrient Deprivation on the Susceptibility of Galleria mellonella Larvae to Infection. Virulence 2012, 3, 497–503. [Google Scholar] [CrossRef]
- Andrea, A.; Krogfelt, K.A.; Jenssen, H. Methods and Challenges of Using the Greater Wax Moth (Galleria mellonella) as a Model Organism in Antimicrobial Compound Discovery. Microorganisms 2019, 7, 85. [Google Scholar] [CrossRef]
- Mowlds, P.; Kavanagh, K. Effect of Pre-Incubation Temperature on Susceptibility of Galleria mellonella Larvae to Infection by Candida albicans. Mycopathologia 2008, 165, 5–12. [Google Scholar] [CrossRef] [PubMed]
- Cook, S.M.; McArthur, J.D. Developing Galleria mellonella as a Model Host for Human Pathogens. Virulence 2013, 4, 350–353. [Google Scholar] [CrossRef] [PubMed]

| G. mellonella breeding and maintenance |
|
| Definition of bacterial growth curves |
|
| G. mellonella larvae infection |
|
| G. mellonella survival assessment |
|
| Time (h) | Avg. OD600 ± SD | Time (h) | Avg. OD600 ± SD |
|---|---|---|---|
| 1 | 0.01516 ± 0.00497 | 13 | 0.6695 ± 0.1306 |
| 2 | 0.08917 ± 0.0566 | 14 | 0.6970 ± 0.1396 |
| 3 | 0.1914 ± 0.0709 | 15 | 0.6955 ± 0.1320 |
| 4 | 0.2519 ± 0.06887 | 16 | 0.7351 ± 0.1236 |
| 5 | 0.3269 ± 0.0552 | 17 | 0.7481 ± 0.1163 |
| 6 | 0.3810 ± 0.04774 | 18 | 0.7621 ± 0.1122 |
| 7 | 0.4152 ± 0.05886 | 19 | 0.7682 ± 0.07287 |
| 8 | 0.4701± 0.08039 | 20 | 0.7768 ± 0.0704 |
| 9 | 0.5109 ± 0.08614 | 21 | 0.7599 ± 0.06782 |
| 10 | 0.5604 ± 0.09189 | 22 | 0.7537 ± 0.04511 |
| 11 | 0.5823 ± 0.08206 | 23 | 0.7474 ± 0.05197 |
| 12 | 0.6180 ± 08842 | 24 | 0.7469 ± 0.04244 |
| Time (h) | Avg. CFU/mL ± SD | Time (h) | Avg. CFU/mL ± SD |
|---|---|---|---|
| 1 | 5.67 × 107 ± 5.77 × 106 | 13 | 4.80 × 108 ± 5.83 × 107 |
| 2 | 8.00 × 107 ± 1.00 × 107 | 14 | 5.14 × 108 ± 1.31 × 108 |
| 3 | 1.98 × 108 ± 8.73 × 107 | 15 | 4.64 × 108 ± 1.17 × 108 |
| 4 | 3.20 × 108 ± 5.35 × 107 | 16 | 5.12 × 108 ± 1.36 × 108 |
| 5 | 4.40 × 108 ± 1.01 × 108 | 17 | 6.20 × 108 ± 2.20 × 108 |
| 6 | 4.28 × 108 ± 1.24 × 108 | 18 | 4.80 × 108 ± 1.88 × 108 |
| 7 | 5.20 × 108 ± 1.87 × 108 | 19 | 6.03 × 108 ± 9.83 × 107 |
| 8 | 5.70 × 108 ± 5.83 × 107 | 20 | 4.95 × 108 ± 1.10 × 108 |
| 9 | 5.55 × 108 ± 2.52 × 107 | 21 | 4.58 × 108 ± 8.16 × 107 |
| 10 | 5.45 × 108 ± 4.20 × 107 | 22 | 5.60 × 108 ± 3.00 × 107 |
| 11 | 5.47 × 108 ± 9.07 × 107 | 23 | 5.00 × 108 ± 1.73 × 107 |
| 12 | 4.60 × 108 ±1.43 × 108 | 24 | 4.85 × 108 ± 6.81 × 107 |
Disclaimer/Publisher’s Note: The statements, opinions and data contained in all publications are solely those of the individual author(s) and contributor(s) and not of MDPI and/or the editor(s). MDPI and/or the editor(s) disclaim responsibility for any injury to people or property resulting from any ideas, methods, instructions or products referred to in the content. |
© 2024 by the authors. Licensee MDPI, Basel, Switzerland. This article is an open access article distributed under the terms and conditions of the Creative Commons Attribution (CC BY) license (https://creativecommons.org/licenses/by/4.0/).
Share and Cite
Banfi, D.; Bianchi, T.; Mastore, M.; Brivio, M.F. Optimization of Experimental Infection of the Animal Model Galleria mellonella Linnaeus 1758 (Lepidoptera: Pyralidae) with the Gram-Positive Bacterium Micrococcus luteus. Insects 2024, 15, 618. https://doi.org/10.3390/insects15080618
Banfi D, Bianchi T, Mastore M, Brivio MF. Optimization of Experimental Infection of the Animal Model Galleria mellonella Linnaeus 1758 (Lepidoptera: Pyralidae) with the Gram-Positive Bacterium Micrococcus luteus. Insects. 2024; 15(8):618. https://doi.org/10.3390/insects15080618
Chicago/Turabian StyleBanfi, Davide, Tommaso Bianchi, Maristella Mastore, and Maurizio Francesco Brivio. 2024. "Optimization of Experimental Infection of the Animal Model Galleria mellonella Linnaeus 1758 (Lepidoptera: Pyralidae) with the Gram-Positive Bacterium Micrococcus luteus" Insects 15, no. 8: 618. https://doi.org/10.3390/insects15080618
APA StyleBanfi, D., Bianchi, T., Mastore, M., & Brivio, M. F. (2024). Optimization of Experimental Infection of the Animal Model Galleria mellonella Linnaeus 1758 (Lepidoptera: Pyralidae) with the Gram-Positive Bacterium Micrococcus luteus. Insects, 15(8), 618. https://doi.org/10.3390/insects15080618

